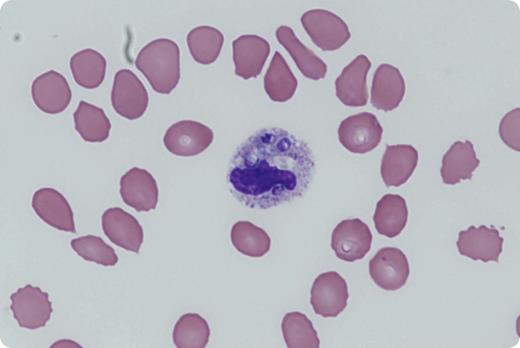
A 51-year-old woman presented with 2 months of fever, chills, diarrhea, dry cough, and progressive dyspnea on exertion. She had a cadaveric renal transplant for immunoglobulin M nephropathy 3 years ago requiring chronic immunosuppression with tacrolimus, mycophenolate, and prednisone. On admission, she had new-onset pancytopenia with a white blood cell count of 2.0 × 109/L (normal range, 3.9-11.7 × 109/L), hemoglobin 6.0 g/dL (normal range, 12-15 g/dL), and a platelet count of 33 × 109/L (normal range, 172-440 × 109/L). Initial peripheral blood smear showed left shift with toxic granulation. On hospital day 3, the patient had a cardiac arrest secondary to acute respiratory failure. On the peripheral blood smear from day 3, hematopathology identified intracellular organisms with thick cell walls and surrounding vacuoles in neutrophils. Liposomal amphotericin was empirically started, resulting in clinical improvement. Cytology from bronchoalveolar lavage and urine antigen confirmed the diagnosis of disseminated histoplasmosis. / The authors thank Dr Kathryn A. Rizzo, Virginia Commonwealth University, for providing the figure.

A 51-year-old woman presented with 2 months of fever, chills, diarrhea, dry cough, and progressive dyspnea on exertion. She had a cadaveric renal transplant for immunoglobulin M nephropathy 3 years ago requiring chronic immunosuppression with tacrolimus, mycophenolate, and prednisone. On admission, she had new-onset pancytopenia with a white blood cell count of 2.0 × 109/L (normal range, 3.9-11.7 × 109/L), hemoglobin 6.0 g/dL (normal range, 12-15 g/dL), and a platelet count of 33 × 109/L (normal range, 172-440 × 109/L). Initial peripheral blood smear showed left shift with toxic granulation. On hospital day 3, the patient had a cardiac arrest secondary to acute respiratory failure. On the peripheral blood smear from day 3, hematopathology identified intracellular organisms with thick cell walls and surrounding vacuoles in neutrophils. Liposomal amphotericin was empirically started, resulting in clinical improvement. Cytology from bronchoalveolar lavage and urine antigen confirmed the diagnosis of disseminated histoplasmosis.
The authors thank Dr Kathryn A. Rizzo, Virginia Commonwealth University, for providing the figure.
A 51-year-old woman presented with 2 months of fever, chills, diarrhea, dry cough, and progressive dyspnea on exertion. She had a cadaveric renal transplant for immunoglobulin M nephropathy 3 years ago requiring chronic immunosuppression with tacrolimus, mycophenolate, and prednisone. On admission, she had new-onset pancytopenia with a white blood cell count of 2.0 × 109/L (normal range, 3.9-11.7 × 109/L), hemoglobin 6.0 g/dL (normal range, 12-15 g/dL), and a platelet count of 33 × 109/L (normal range, 172-440 × 109/L). Initial peripheral blood smear showed left shift with toxic granulation. On hospital day 3, the patient had a cardiac arrest secondary to acute respiratory failure. On the peripheral blood smear from day 3, hematopathology identified intracellular organisms with thick cell walls and surrounding vacuoles in neutrophils. Liposomal amphotericin was empirically started, resulting in clinical improvement. Cytology from bronchoalveolar lavage and urine antigen confirmed the diagnosis of disseminated histoplasmosis.
The authors thank Dr Kathryn A. Rizzo, Virginia Commonwealth University, for providing the figure.
For additional images, visit the ASH IMAGE BANK, a reference and teaching tool that is continually updated with new atlas and case study images. For more information visit http://imagebank.hematology.org.